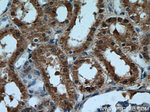
ALDH8A1 Antibody in Immunohistochemistry (Paraffin) (IHC (P))

Search
Proteintech
ALDH8A1 Polyclonal Antibody
{{$productOrderCtrl.translations['antibody.pdp.commerceCard.promotion.promotions']}}
{{$productOrderCtrl.translations['antibody.pdp.commerceCard.promotion.viewpromo']}}
{{$productOrderCtrl.translations['antibody.pdp.commerceCard.promotion.promocode']}}: {{promo.promoCode}} {{promo.promoTitle}} {{promo.promoDescription}}. {{$productOrderCtrl.translations['antibody.pdp.commerceCard.promotion.learnmore']}}
产品信息
21602-1-AP
种属反应
宿主/亚型
分类
类型
抗原
偶联物
形式
浓度
规格
纯化类型
保存液
内含物
保存条件
运输条件
产品详细信息
Immunogen sequence: CMHYTVRAP VGVAGLISPW NLPLYLLTWK IAPAMAAGNT VIAKPSELTS VTAWMLCKLL DKAGVPPGVV NIVFGTGPRV GEALVSHPEV PLISFTGSQP TAERITQLSA PHCKKLSLEL GGKNPAIIFE DANLDECIPA TVRSSFANQG EICLCTSRIF VQKSIYSEFL KRFVEATRKW KVGIPSDPLV SIGALISKAH LEKVRSYVKR ALAEGAQIWC GEGVDKLSLP ARNQAGYFML PTVITDIKDE SCCMTEEIFG PVTCVVPFDS EEEVIERANN VKYGLAATVW SSNVGRVHRV AKKLQSGLVW TNCWLIRELN LPFGGMKSSG IGREGAKDSY DFFTEIKTIT VKH (136-487 aa encoded by BC113862)
靶标信息
This protein belongs to the aldehyde dehydrogenases family of proteins. It plays a role in a pathway of 9-cis-retinoic acid biosynthesis in vivo. This enzyme converts 9-cis-retinal into the retinoid X receptor ligand 9-cis-retinoic acid, and has approximately 40-fold higher activity with 9-cis-retinal than with all-trans-retinal. Therefore, it is the first known aldehyde dehydrogenase to show a preference for 9-cis-retinal relative to all-trans-retinal. Two transcript variants encoding distinct isoforms have been identified for this gene.
仅用于科研。不用于诊断过程。未经明确授权不得转售。
篇参考文献 (0)
生物信息学
蛋白别名: 2-aminomuconic semialdehyde dehydrogenase; Aldehyde dehydrogenase 12; Aldehyde dehydrogenase family 8 member A1; aldehyde dehydrogenase family protein; Retinal dehydrogenase 4; retinal dehydrogenase type 4; unnamed protein product
基因别名: ALDH12; ALDH8A1; DJ352A20.2; Raldh4
UniProt ID: (Human) Q9H2A2, (Mouse) Q8BH00
Entrez Gene ID: (Human) 64577, (Mouse) 237320, (Rat) 685750